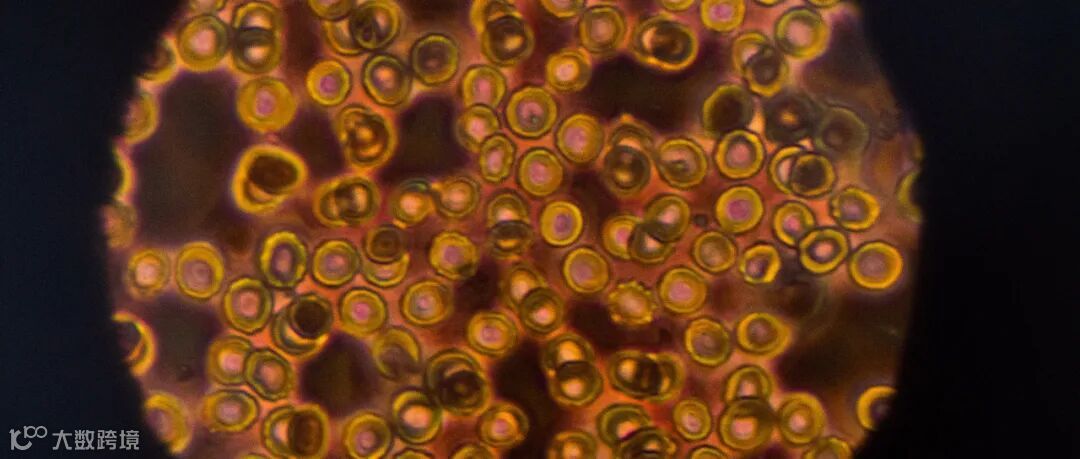

在女性与衰老这场拉锯战中,起着决定性作用的便是——卵巢,它可以说是操控着女人青春和衰老的魔力之手,会影响到女性皮肤、神经、免疫等400多个组织器官的青春与活力。
女性卵巢有四个重要功能
1.分泌激素,管理生理周期;
2.储存卵子并排卵,掌控生育功能;
3.调节内分泌,影响健康美丽;
4.保护心脑血管、骨骼健康。
女性一生中会排出400个左右的成熟卵子,正常情况下每次月经会排出1个卵子,而年龄是影响卵巢生殖功能的最大因素。受孕功能在20-30岁的时候是最好的,30岁以后卵巢的功能开始下降,37.5岁进入更年期,50岁左右进入绝经状态,这就是卵巢一生的功能状态。
卵巢早衰的疾病概况及诊断标准
卵巢功能早衰(POF)是指女性40岁之前由于多种病因出现卵巢功能衰竭,表现为雌激素缺乏、促性腺激素水平升高等指标变化,病情则以闭经或者不孕为主。被认为是导致不孕的“不治之症”。
该病的诊断标准是指: 40岁以前出现至少4个月以上闭经, 并有2次或促卵泡激素FSH>40IU/L (两次检查间隔1个月以上) , 雌二醇<73.2pmol/L。这种疾病的发病率在育龄女性中超过1%。
近年来卵巢早衰呈上升和年轻化趋势,卵巢早衰对女性生殖健康的两大威胁主要是雌激素水平降低及生育能力丧失,雌激素水平降低增加了女性患骨质疏松和冠心病的危险。而处于生育期的女性提早闭经、生育能力丧失,容易出现抑郁、焦虑等心理问题。
很多女性因缺乏专业知识,对卵巢功能衰退并不在意,不注重月经量等问题,甚至有些女性到了生育年龄发现不孕等问题才到医院就诊,这样会错过了延缓卵巢早衰的机会。
卵巢中卵的数量是只减不增的,如果卵巢早衰,往往只能通过药物治疗进行控制或改善,但不可逆。所以,避开危险因素,是防止卵巢早衰最重要的方法。
常见的危险因素主要有:自身免疫性卵巢损伤、染色体和基因缺陷、感染因素、医源性因素等。
卵巢早衰的临床治疗方法
临床上主要有雌激素替代治疗以及促排卵治疗、免疫抑制剂治疗、卵移植、DHEA治疗等常用的治疗方法,但收效甚微,只有5%-10%的患者经过积极治疗后,在短期内有望恢复卵巢功能,甚至重获生育能力。
而且这些临床治疗方法有一定的局限性,例如需要长期摄入药物、存在副作用等,虽然可以缓解症状、促进生育,但无法从根本上恢复卵巢功能,因此患者需要一种能够安全有效的治疗方法。
近几年,随着干细胞疗法的发展,卵巢早衰是可以通过干细胞治疗以达到延缓甚至阻止卵巢的提前衰老。
干细胞疗法为干预卵巢早衰提供新思路
随着再生医疗快速发展,目前干细胞在卵巢早衰领域应用被人们关注。干细胞是一种具有自我更新、不断增殖和多向分化潜能的细胞。
干细胞具有多分化潜能及低免疫源特性,取材方便,体外培养增殖容易,在维持机体内环境稳定、衰老、组织损伤修复及调节炎症性疾病中发挥重要作用。
干细胞还具有高增殖潜力,自我更新潜力、多向分化潜能,有造血支持、免疫调节和组织修复等优点,大量研究已证明干细胞可改善卵巢结构和功能,成为干预卵巢早衰较好办法。
干细胞修复卵巢案例
36岁的李女士结婚不久便出现闭经现象,经医院医生诊断为卵巢功能衰竭。经常规治疗后始终无法怀上小孩。通过干细胞再生技术,终于实现了当母亲的梦,顺利诞下一个健康的男婴。
随着一声响亮的哭啼声,李女士激动地表达:他(宝宝)出生的那一刻,我觉得什么都值得了!
32岁的王女士已有2年时间都存在月经紊乱的症状,甚至有半年不来月经的经历,想要二胎成了难题。王女士接受了静脉脐带间充质干细胞移植,仅仅经过4周的治疗便有了早孕反应,并产下了一位6斤多重的健康男婴。
南京大学医学院附属鼓楼医院在脐带间充质干细胞复合胶原卵巢移植的方式治疗卵巢早衰所致的不孕症的研究结果表明:胶原/脐带间充质干细胞移植能够改善患者的卵泡活化和卵泡生长,并有助于卵巢功能的长期恢复,包括卵巢血流和雌二醇水平。而且,有2例患者在移植后成功受孕。
干细胞疗法有效干预卵巢早衰六种机制
1. 旁分泌
干细胞可分泌多种细胞因子 (如血管内皮生长因子、肝细胞生长因子、类胰岛素一号增长因子等) ,抑制细胞凋亡,修复受损组织细胞。
2. 归巢性
干细胞定植于受损伤部位并进行分化,部分补偿或替代修复其功能。
3. 免疫调节
干细胞通过免疫调节作用,抑制机体免疫反应,促进受损组织自身修复。
4. 抗纤维化
干细胞可通过修复卵巢间质防止卵巢纤维化,从而对受损卵巢起到保护作用。
5. 多向分化潜力
干细胞进入损伤卵巢后可能直达损伤部位,并分化成部分血管内皮细胞,提供营养支。
6. 调控作用
干细胞可改变部分基因表达,并通过基因改变达到调控卵巢功能的作用。
干细胞的优势
干细胞促进卵巢再生通过增加上调卵巢干细胞功能蛋白的表达,促进细胞循环控制蛋白水平,最终促进卵巢再生。
干细胞恢复卵巢功能干细胞通过激活宿主卵子或间接调节卵巢微环境减少颗粒细胞凋亡恢复卵巢功能。
恢复卵巢生殖功能干细胞可减少环磷酰胺
对卵巢组织损伤,恢复卵巢内分泌和生殖功能。
--------END--------
如涉及侵权请联系我们删除

